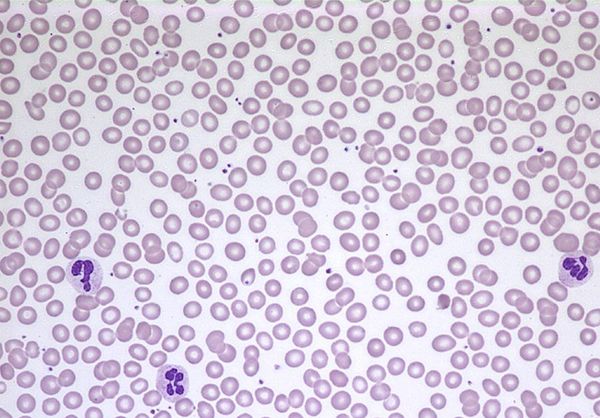

setTimeout(function(){
window.print();
},2000)
Datenblatt Blut unter dem MikroskopArtikel-Nr.: P1449100 ![]() Prinzip Mithilfe eines fertigen Präparats wird menschliches Blut unter dem Mikroskop beobachtet. Ziel ist es, die verschiedenen Phasen der Zellteilung zu erkennen und den sicheren Umgang mit dem Mikroskop zu üben. Aufgaben
Lernziele
Vorteile
|